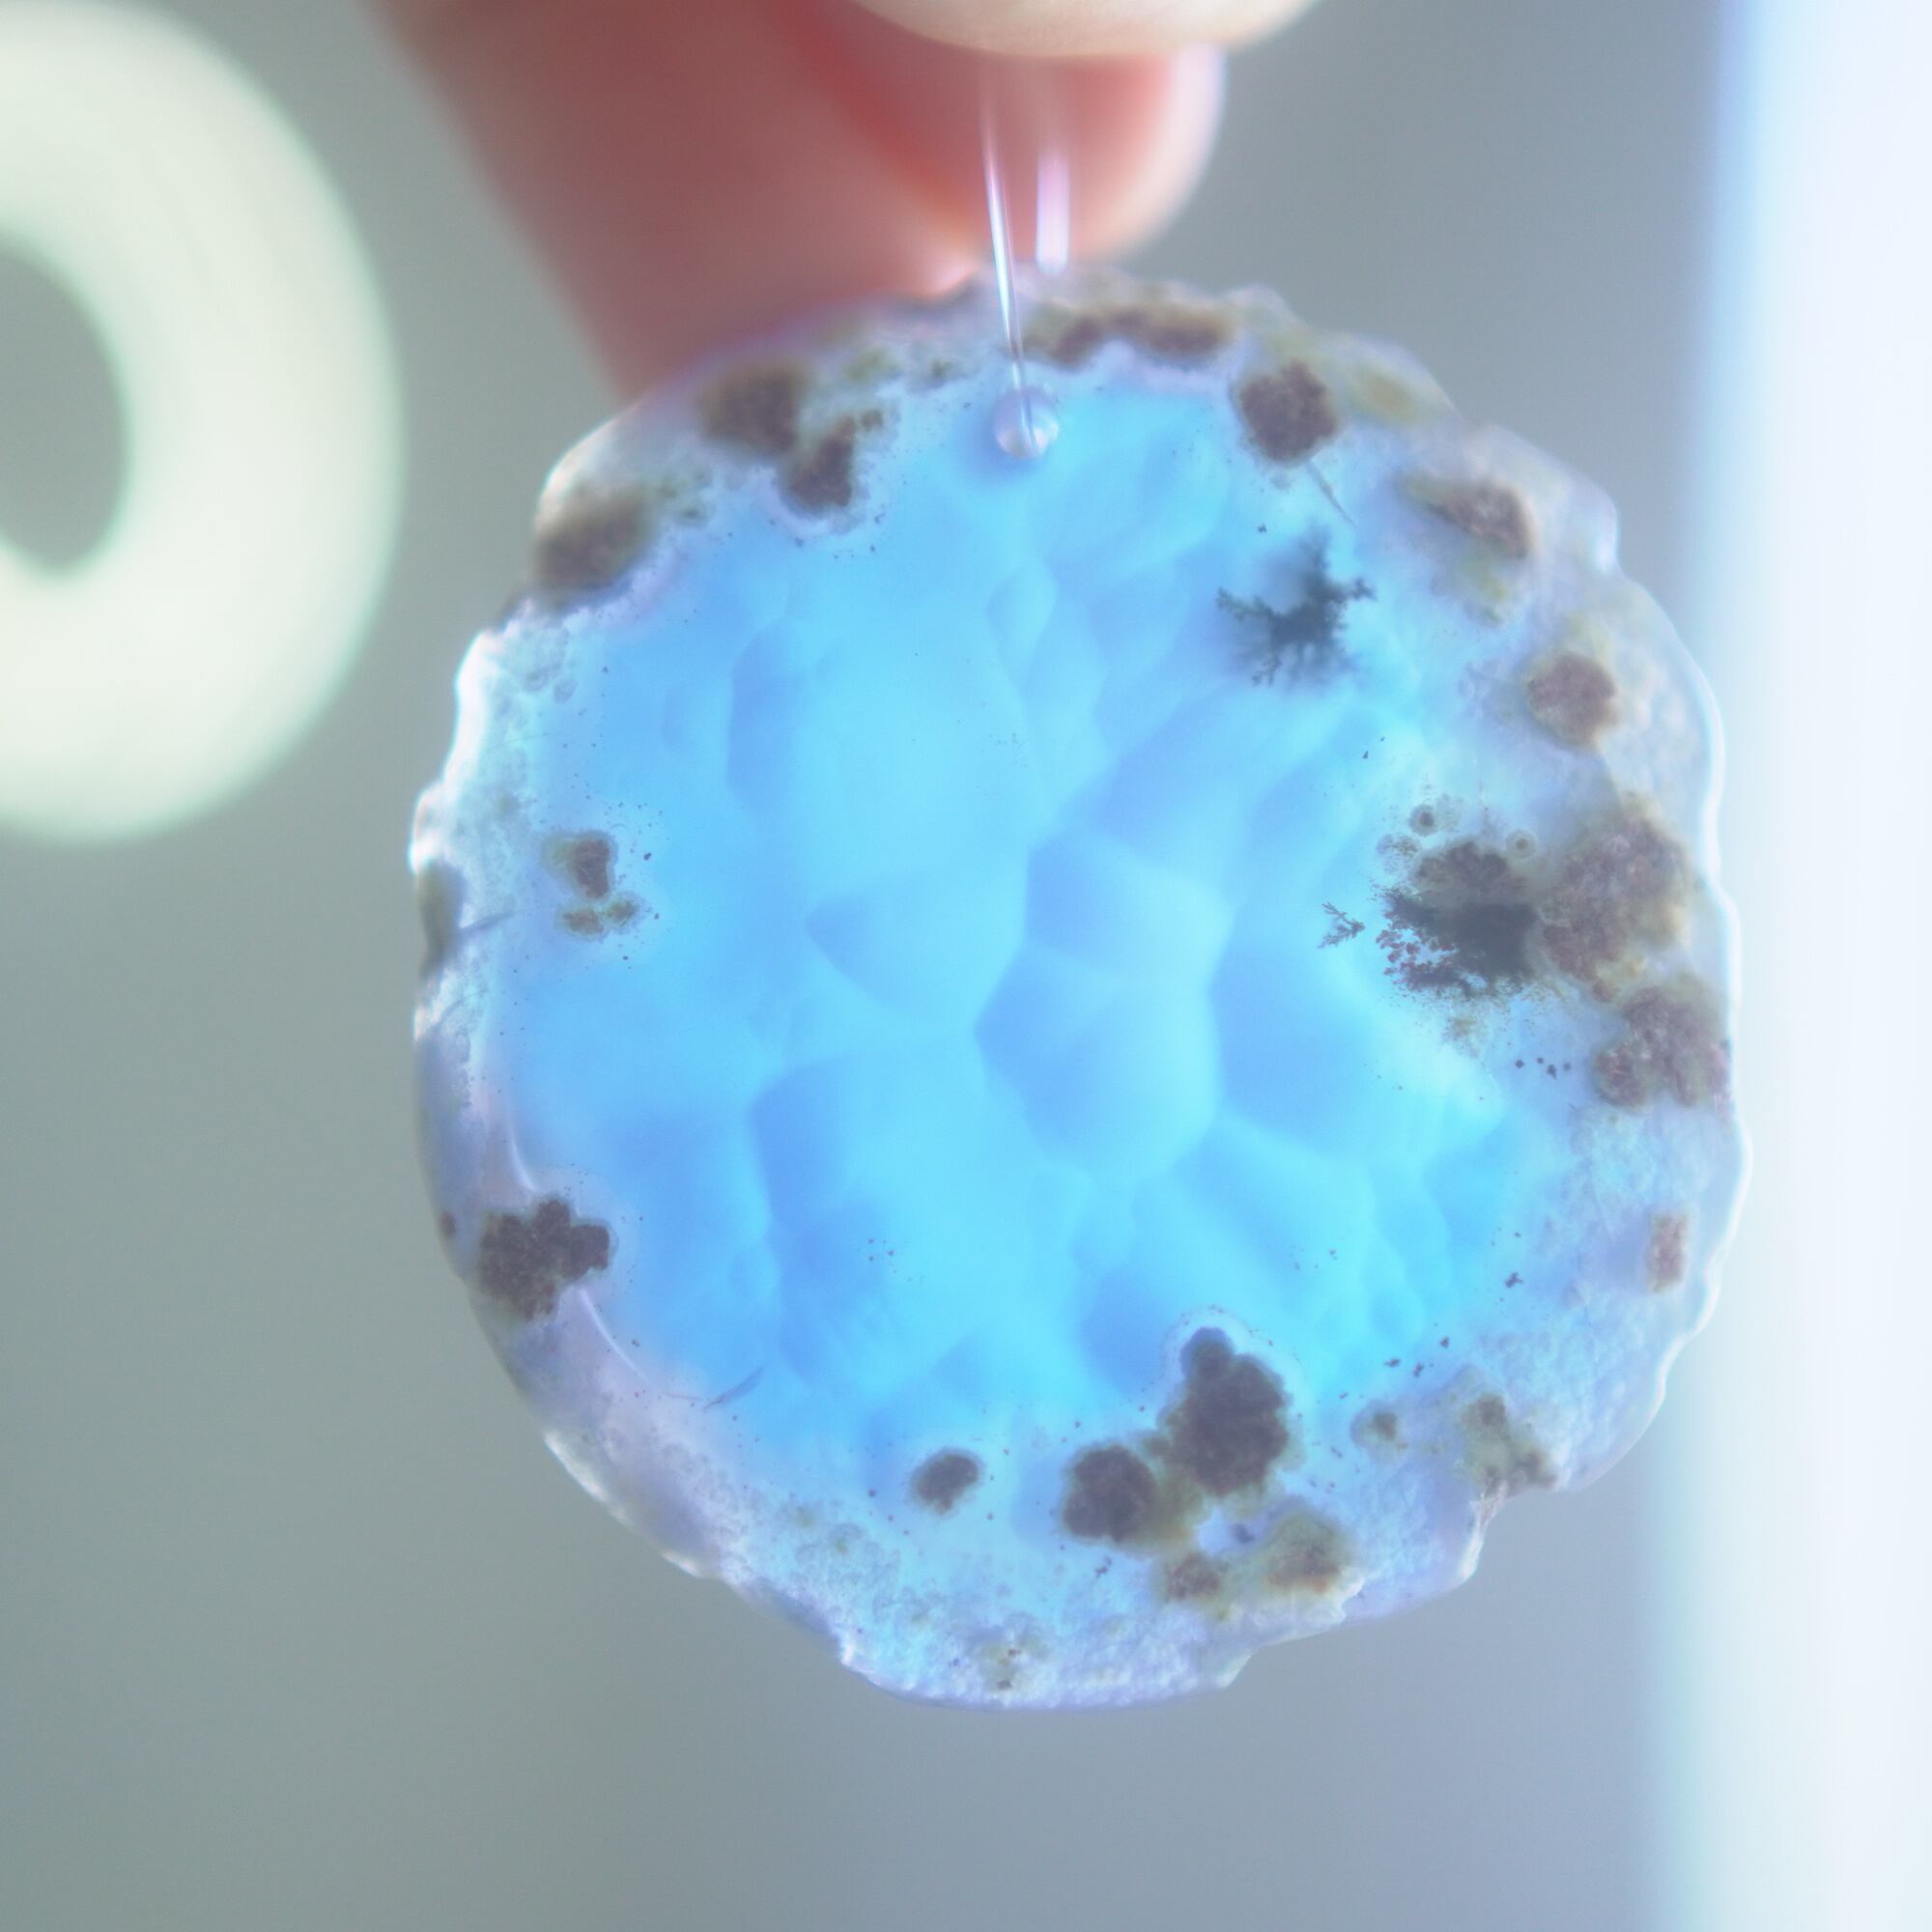

SYUUSUI - アゲートヒーリングチャイム / Agate Healing Chime 1458
※こちらのチャイムは写真の商品の1点ものになります※
※背景に映っているサンキャッチャーは別ページの商品となります※
秋水をイメージしたアゲートのヒーリングチャイム。
風情のある水の流れようなブルー~ベージュ系の石たちが美しい組み合わせです。
♬音色試聴ムービーはこちら↓
https://youtube.com/shorts/KXfN_lj8b9I?si=-VN2-Nn_lNI4cmu3
【※リングパーツについて】
2024.12~ チャイム上部の、ナイロンコードを繋いでいるパーツを木製リングからシルバーカラーの細めのメタルリングに変更しています。細かなポイントながら、今までよりさらに天然石の美しさを生かしたデザインにバージョンアップしています。
従来通りの、ナチュラルな木製リングにも変更可能ですので、ご希望のパーツ素材をカートに入れる前にプルダウンオプションよりお選びください
【LENGTH】
一番上の取っ手のリングの先から一番下のメノウの下まで全長
63cm
(コード除くメノウ部分だけでおよそ26cm前後です)
メノウひとつあたりの長さおよそ6~8.5cm
※長さは無料で調整できます。石の間隔等は変えず、上部の長さだけを調整する形で最短40cm~可能ですので、ご希望の場合はお買い物時に備考欄にご記載ください
【MATERIAL】
Agate Slice , Nylon Cord , Metal
先端は金属の輪になっておりますので、S字フックなどが別途必要になります
✧✧✧
色柄や音色が美しく、空間浄化やサンキャッチャーにもなる瑪瑙のチャイム。
KOHHAのアゲートヒーリングチャイムは、海外で販売されている7連の瑪瑙風鈴をベースにして、音色やデザイン性に拘り、新しく昇華させたものです。
元々の瑪瑙風鈴とは使っている石の大きさや厚みが異なり、こちらのものはそれ同士重ねるだけでは特別音が鳴らない厚さのスライスアゲートを使用しているのですが、間に2本、細長い形状のアゲートを挟むことによって音が鳴る仕組みになっています。(もう少し変則的な組み合わせ方で音が鳴っていることもあります)
重ねる石同士の側面の加工状態によっても良い音が鳴ったり鳴らなかったり、石の見た目だけで組み合わせを決められないことが難しいポイントでもあるのですが、そんな中、たくさんの石の中から選ばれた5枚のスライスアゲートから出来上がったチャイムたちは、どこか悠々自適に空を泳ぐ妖精のようでもあり、それぞれの音を楽しそうに奏でてくれます。
アゲートは同じ染色カラーでも形や柄・濃淡などにかなり差があるためすべて一点ものとなり、一点一点響きも異なりますので、気になったチャイムがあれば是非ムービーもご覧くださいませ。
また、透明感が魅力でもあるので、窓際で自然光を通した際と、室内灯の下で光を通さずに見る際、異なる表情を見せてくれますのでその違いも是非お楽しみいただけたらと思います。
そしてカーテン越しではなく直射日光を当てた際のサンキャッチャーとしてのチャイムも、ピカピカとした美しい光をお部屋の中に運んでくれます。
癒しアイテムがお好きな方や原石感のある天然石がお好きな方、 光や風、色どりあふれるもの、透明感あるもの、などがお好きな方に是非。
チャイムが放つ光の粒や、ふとしたときにチリンと鳴る音色に、光や風を感じたり、 忙しない毎日の中でこの世界がとても美しいことを思い出すきっかけになれば嬉しいです。
【ATTENTION】
✧瑪瑙の濃い色は染色によるもので、水に濡れた布で擦ると多少色落ちしますが、汚れが気になる時は若干の色落ち前提で水を軽く含ませた布やティッシュでやさしく拭いていただくことは大丈夫です。また、画像のような細かなヒビ・カケはスライスメノウの加工上避けられないことが多く、チャイムとしての機能や全体の外観を著しく損なうものを除き、見た目の完璧さ<音色の響きや石のもつ美しさ重視で選んで使用しております✧
✧染色の石なので耐光性(光による経年でのカラー変化の耐性)に優れているわけではなくベランダなど一日の中で長時間強い日光に当たるような場所に飾られるのはおすすめしないのですが、陽光に透かした時にだけ真価を発揮する美しさがありますので、是非、時折翳したりして光と一緒にお楽しみいただけたらと思います。特に濃い鮮やかな色など、色変化が気になられる場合は、日光のあまり当たらない場所に飾ってくださいね✧
✧繊細な素材の為、落下などには十分ご注意くださいませ✧
――――――――――✶――――――――――
✧✧✧ご購入をお考えの方はこちらもご一読ください✧✧✧
✶決済方法について
未払いによるキャンセルが多くなっており、
コンビニ決済と銀行振込につきましては、
決済の選択肢が他にない場合にのみお選びいただけますと大変助かります
(一点ものの商品も多数ありますので、必ずご購入がお決まりの場合にのみ購入画面にお進みください)
ご事情があり期日内の入金が難しい場合はご連絡いただけましたら別途対応させていただきますので、未払いによるキャンセルは避けていただきますよう、どうぞよろしくお願いいたします。
✶発送スケジュールについて
ご購入より3日以内発送となっております。
(Light Healing Crystal のサンキャッチャーシリーズと同時購入の場合はおまとめして一週間以内でのご発送となります)
✶パッケージについて
通常で、ご自宅用・ギフト用関わらず画像のようなパッケージで発送させていただいております。
→真ん中にリボンのある(LIGHT - NEON)
→シンプルな横結びの(WATER - SILVER)
2種類のパターンがありますので、デザインのご希望ありましたらプルダウンオプションよりご選択ください。
※写真だとわかりづらいですがオーロラ色の部分は偏光色のステッカーでいずれも同じものです。
※特にご指定なしの場合、リボン等すべてアソートでさせていただいております。
✶ギフト用の場合
また、お包み方法は同じなのですが、お渡ししやすいよう、納品書等と分けて、商品だけを内袋で小分けにして梱包しております。
簡単なものにはなりますが中身の見える透明のお渡し袋を同梱させていただくこともできます。
・ギフト用(お渡し袋はなしでOK)
・ギフト用(透明お渡し袋を希望する)
→カートに入れる前にプルダウンオプションでご選択ください